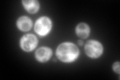
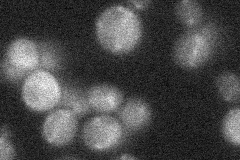

View description
Ribosomal protein L30 of the large (60S) ribosomal subunit, nearly identical to Rpl24Ap and has similarity to rat L24 ribosomal protein; not essential for translation but may be required for normal translation rate
Localization:
Intensity:
Fold change:
Significance:
-
C’ GFP library in SD
cytosol704.45 -
N' NOP1pr-GFP in SD

below threshold15.1982 -
N' TEF2pr-mCherry in SD

cytosol8.1897 -
N' NATIVEpr-GFP in SD
punctate17.9118 -
N' TEF2pr-VC and Cyto-VN in SD

cytosol77.0135 -
C’ GFP library in SD+DTT

cytosol552.110.78No -
C’ GFP library in SD+H2O2

cytosol599.860.85No -
C’ GFP library in Starvation Media

cytosol410.090.58No -
C’ GFP library on the background of Pup2-DaMP

cytosol -
C’ GFP library on the background of CCT mutant

cytosol637.9690.905615No
